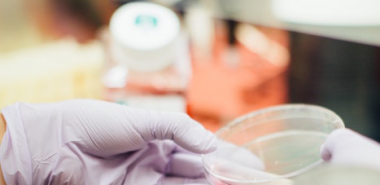

Singapore | English 中文 |
Bangladesh | English |
India | English |
Indonesia | English Bahasa |
Malaysia | English 中文 |
Myanmar | English Burmese |
Philippines | English |
Sri Lanka | English |
UAE | English Arabic |
Vietnam | English Tiếng Việt |
CME Empowerment Series 2021

Understanding Cancer and Beyond – Continuing Medical Education (CME) Empowerment Series aims to provide effective platforms for medical professionals to acquire, share and exchange knowledge & clinical experience.
In addition to knowledge sharing, a bigger objective is to forge working relationships, build a vibrant doctor community and strengthen competencies in the delivery of patient care.
Pregnancy and Gynaecologic Cancer
Gynaecologic cancers include ovarian, endometrial and cervical cancer. Germ cell ovarian tumours can occur in ladies of child bearing age even during pregnancy, so can cervical cancer. Gestational Trophoblastic disease is endometrial cancer associated with pregnancy.
Join Dr See as she relooks at the statistics and management of gynaecologic cancers around the topic of pregnancy.
Speakers

Senior Consultant
Medical Oncology
Parkway Cancer Centre
DATE
Thursday, 08 April 2021
TIME
1PM – 2PM SGT
PLATFORM
Online Webinar
(Registration closes 1 hour before the event start date.)
Cancer Pain Management -
Tips For The Busy Clinic Doctors
Cancer pain is a common symptom faced by cancer patients. With advances in cancer treatment, family physicians and specialists are likely to see more patients living with cancers and some with cancer pain issues. In this talk, we will share some cancer pain management tips at the clinic level.
Speakers

Dr Kok Jaan Yang
Senior Consultant
Palliative Medicine
Parkway Cancer Centre

Consultant
Anaesthesiologist
Integrative Pain Centre
DATE
Thursday, 22 April 2021
TIME
1PM – 2PM SGT
PLATFORM
Online Webinar
(Registration closes 1 hour before the event start date.)
Parkway Cancer Centre Tumour Board & Oncology Update
Parkway Cancer Centre (PCC) Tumour Board is a multi-disciplinary discussion platform where unusual or challenging oncology cases are presented for discussion. To enhance the learning experience for all participants, we incorporate an oncology update.
For this session, the cases will be focused on:
- Recurrent Hepatocellular Carcinoma & Follicular Lymphoma
- Metastatic Breast Cancer
Speakers

Chairperson of Tumour Board
Senior Consultant
Medical Oncology
Parkway Cancer Centre

Medical Director
Hepatopancreatobiliary Surgery
Liver transplantation
GLAD Clinic

Consultant
Bone Marrow Transplant Surgeon
Medical Oncology
Manipal Hospital, Bangalore
DATE
Thursday, 29 April 2021
TIME
5PM – 6.30PM SGT
PLATFORM
Online Webinar
(Registration closes 1 day before the event start date.)
Parkway Cancer Centre Tumour Board & Oncology Update
Parkway Cancer Centre (PCC) Tumour Board is a multi-disciplinary discussion platform where unusual or challenging oncology cases are presented for discussion. To enhance the learning experience for all participants, we incorporate an oncology update.
For this session, the cases will be focused on:
- Metastatic melanoma with neurotoxicity to immunotherapy
- Metastatic Gallbladder Cancer
Guest speaker Dr Matthew G. Krebs from the United Kingdom will also give an oncology update on the Clinical Utility of NGS Comprehensive Genomic Profiling in Cancer Management .
Speakers

Senior Consultant
Medical Oncology
Parkway Cancer Centre

Senior Consultant
Diagnostics Radiologist
Mount Elizabeth Hospital

Dr Brendan Pang
Consultant
Pathologist
Medical Oncology
ParkwayHealth Laboratory

Consultant
Neurologist
Ng John Neurology Practice

Honorary Consultant in Medical Oncology
Deputy Theme Lead for Clinical Trials in lung cancer
Clinical Senior Lecturer in Experimental Cancer Medicine
The University of Manchester and The Christie NHS Foundation Trust
University College London (UCL) Lung Cancer Centre of Excellence
Manchester, United Kingdom
DATE
Thursday, 20 May 2021
TIME
5PM – 6.30PM SGT
PLATFORM
Online Webinar
(Registration closes 1 day before the event start date.)
Potentially Resectable Pancreatic Adenocarcinoma -
Current Treatment Approaches
Pancreatic adenocarcinoma is a lethal condition with poor outcomes and an increasing incidence. While most patients present with advanced disease, approximately 20% of patients have surgically resectable disease. In the latter group, surgical resection is the only treatment that offers potential for cure. The addition of chemotherapy has also been shown to improve survival rates. Patients with borderline resectable disease may be considered for pre-operative therapy with the aim of conversion to resectability. This presentation will review the current role and sequencing of combined modality therapy in the management of resectable pancreatic adenocarcinoma.
Speakers

Senior Consultant
Medical Oncology
Parkway Cancer Centre

Consultant
Hepatobiliary & Pancreatic Surgeon
Hepatobiliary & Pancreatic Surgery Centre
DATE
Thursday, 27 May 2021
TIME
1PM – 2PM SGT
PLATFORM
Online Webinar
(Registration closes 1 day before the event start date.)
Management of Anaemia: Pearls and Pitfalls
Although anaemia is a common medical condition, it can be suboptimally managed because of possible misdiagnosis or ineffective treatment.
Important clinical pointers and accurate interpretation of laboratory results will be discussed.
Speaker

Senior Consultant
Haematology
Parkway Cancer Centre
DATE
Saturday, 5 June 2021
TIME
2PM – 3PM SGT
PLATFORM
Online Webinar
(Registration closes 1 day before the event start date.)
Haematological Diseases: The Masquerade Ball of Symptoms and Interpreting Other Tests Frequently Ordered by the Haematologist
Haematological diseases present with a myriad of symptoms which can mimick the ways other conditions present. Some clinical signs and symptoms are non-specific and should be corroborated with key laboratory findings for an accurate diagnosis.
Different clinical presentations of various haematological diseases will be discussed with case studies. In this talk, we will also focuses on some commonly ordered blood tests that can be abnormal in haematological conditions (other than the FBC!). Tests that we will discuss are the prothrombin (PT) and partial thromboplastin time (PTT), ESR, globulin fraction and protein electrophoresis, and blood tests used when haemolysis is suspected.
Speaker

Senior Consultant
Haematology
Parkway Cancer Centre

Senior Consultant
Haematology
Parkway Cancer Centre
DATE
Thursday, 8 July 2021
TIME
1PM – 2PM SGT
PLATFORM
Online Webinar
(Registration closes 1 day before the event start date.)
Parkway Cancer Centre Tumour Board & Oncology Update
Parkway Cancer Centre (PCC) Tumour Board is a multi-disciplinary discussion platform where unusual or challenging oncology cases are presented for discussion. To enhance the learning experience for all participants, we incorporate an oncology update.
For this session, the cases will be focused on:
- Hepatocellular Carcinoma
- Gastrointestinal Stromal Tumour
Guest speaker Prof Christoph Springfield will also give an oncology update on NTRK inhibitors.
Speakers

Chairperson of Tumour Board
Senior Consultant
Medical Oncology
Parkway Cancer Centre

Senior Consultant
Diagnostics Radiologist
Mount Elizabeth Hospital

Dr Brendan Pang
Consultant
Pathologist
Medical Oncology
ParkwayHealth Laboratory

Prof Christoph Springfeld
Managing Senior Physician and Chief Senior Physician
Medical Oncologist
Department of Medical Oncology
Heidelberg University Hospital
DATE
Thursday, 22 July 2021
TIME
5PM – 6.30PM SGT
PLATFORM
Online Webinar
(Registration closes 1 day before the event start date.)
The ABCs of Viral Hepatitis and Liver Cancer and Non-surgical management of Hepatocellular Carcinoma
Viral hepatitis can cause a myriad of symptoms and both short- and long-term sequele.
The management of HCC depends on a multidisciplinary approach with input from gastroenterologist, hepatobiliary surgeon, interventional radiologists , medical and radiation oncologists.
This talk will focus on chronic viral hepatitis B & C, from diagnosis to complications such as cirrhosis, liver cancer and the non-surgical management of HCC.
Speaker

Senior Consultant
Medical Oncology
Parkway Cancer Centre

Senior Consultant
Gastroenterology and Hepatology
Kieron Lim Gastroenterology
DATE
Thursday, 12 August 2021
TIME
1PM – 2PM SGT
PLATFORM
Online Webinar
(Registration closes 1 day before the event start date.)
Parkway Cancer Centre Tumour Board & Oncology Update
Parkway Cancer Centre (PCC) Tumour Board is a multi-disciplinary discussion platform where unusual or challenging oncology cases are presented for discussion. To enhance the learning experience for all participants, we incorporate an oncology update.
For this session, there will be 2 case presentations on Multiple Myeloma.
Guest speaker Prof Michele Cavo will also give an oncology update on
(R)evolution of multiple myeloma treatment strategies with Darzalex.
Speakers

Chairperson of Tumour Board
Senior Consultant
Haematology
Parkway Cancer Centre

Senior Consultant
Haematology
Parkway Cancer Centre

Prof Michele Cavo
Professor of Haematology
Head of Seràgnoli
Institute of Haematology
Bologna University School of Medicine
DATE
Thursday, 26 August 2021
TIME
5PM – 6.30PM SGT
PLATFORM
Online Webinar
(Registration closes 1 day before the event start date.)
Management of Neck Lumps and Diffuse Large B-cell Lymphoma: The Commonest Type of Lymphoma
Neck lumps are commonly seen in clinical practice. There are many causes of neck lumps and a systemic approach is required to arrive at the diagnosis. The appropriate investigations and treatment can then be recommended for each clinical situation.
Diffuse Large B-cell Lymphoma is the commonest type of lymphoma. Under this diagnosis is a large heterogeneous group of different subtypes with various clinical and histological characteristics. Generally considered an aggressive lymphoma, it requires a prompt recognition and early treatment to achieve optimal outcomes.
Speaker

Senior Consultant
Otolaryngology
Novena ENT-Head & Neck Surgery Centre

Senior Consultant
Haematology
Parkway Cancer Centre
DATE
Saturday, 4 September 2021
TIME
2PM – 3PM SGT
PLATFORM
Online Webinar
(Registration closes 1 day before the event start date.)
Revolutions in Radiation Therapy (RT): Surface Guided RT (SGRT) & Proton Therapy
A large percentage of cancer patients receive radiation therapy as a sole primary treatment, or in combination with surgery, chemotherapy and immunotherapy. When radiation is directed to cancer cells, the radiation absorbed results in DNA damage and if severe enough, leads to cancer cell death. Unfortunately, surrounding normal tissue may be affected too.
The aim of radiation therapy is to deliver effective doses of highly focussed radiation beams targeting the cancerous tissues whilst sparing surrounding healthy tissues from permanent damage. Over the course of the treatment, the goal is to set up the patient in the treatment position and ensure that each delivery is accurate as according to the first treatment set up, taking into account patient’s organ motion changes.
The first talk introduces SGRT in the evolvement of Image Guided RT. Advances in technology provides solution for intra-fraction and inter-fraction patient/organ movements. SGRT, using capabilities of X-rays, optical cameras and thermal cameras makes it possible to treat patients precisely in the shortest possible time.
The second talk introduces proton therapy in radiation treatment. In cancer treatment, the ionising radiation delivered to cancer cells are either photons or particles. The former consists of high energy X-rays and gamma rays whilst the latter include protons, electrons, neutrons and heavy carbon ions. The promise of proton beam therapy is in being able to reduce normal tissue toxicities compared to conventional radiation and the potential for dose escalation to achieve a higher control rate.
Speaker

Senior Consultant
Radiation Oncology
Parkway Cancer Centre

Senior Consultant
Radiation Oncology
Parkway Cancer Centre
DATE
Thursday, 9 September 2021
TIME
1PM – 2PM SGT
PLATFORM
Online Webinar
(Registration closes 1 day before the event start date.)
Parkway Cancer Centre Tumour Board & Oncology Update
Parkway Cancer Centre (PCC) Tumour Board is a multi-disciplinary discussion platform where unusual or challenging oncology cases are presented for discussion. To enhance the learning experience for all participants, we incorporate an oncology update.
For this session, the caseswill be focused on:
Left Thigh Rhabdomyosarcoma
Guest speaker Dr Khaw Seong Lin will also give an oncology update on CART Therapy: Setting up to deliver a breakthrough immunotherapy in blood cancer.
Speakers

Chairperson of Tumour Board
Senior Consultant
Medical Oncology
Parkway Cancer Centre

Senior Consultant
Diagnostics Radiologist
Mount Elizabeth Hospital

Dr Brendan Pang
Consultant
Pathologist
Medical Oncology
ParkwayHealth Laboratory

Orthopaedic Surgeon
Orthopaedic Surgery
Mount Elizabeth Hospital

Senior Consultant
Radiation Oncology
Parkway Cancer Centre

Dr Khaw Seong Lin
Paediatric Oncologist
Leukaemia Stream Clinical Lead and Head of CART Cell Program
Children's Cancer Foundation Clinical Research Fellow
Honorary Senior Fellow
Department of Paediatrics
The University of Melbourne
DATE
Thursday, 23 September 2021
TIME
5PM – 6.30PM SGT
PLATFORM
Online Webinar
(Registration closes 1 day before the event start date.)
Evolutions, Recent Advances and The Future of Cancer Treatment
Cancer is a leading cause of morbidity and mortality world-wide as well as in Singapore. Despite many advances in cancer management, the control of cancer spread remains a challenge.
Traditionally, cytotoxic chemotherapy and hormonal therapy have been the only treatment options.
Over the past 3 decades, targeted agents, monoclonal antibodies and immunotherapy have demonstrated superiority when used singly or in combination with chemotherapy, resulting in higher efficacy in terms of response rates, longer progression-free survival and cure rates.
The future of oncology lies in the discovery and development of new drugs/agents as well as personalized cancer therapy based on molecular profiling of the individual’s cancer.
Speakers

Medical Director and Senior Consultant
Medical Oncology
Parkway Cancer Centre

Senior Consultant
Haematology
Parkway Cancer Centre
DATE
Thursday, 14 October 2021
TIME
1PM – 2PM SGT
PLATFORM
Online Webinar
(Registration closes 1 day before the event start date.)
Parkway Cancer Centre Tumour Board & Oncology Update
Parkway Cancer Centre (PCC) Tumour Board is a multi-disciplinary discussion platform where unusual or challenging oncology cases are presented for discussion. To enhance the learning experience for all participants, we incorporate an oncology update.
For this session, the case will be focused on:
Melanoma
Dr Richard Quek will also give an oncology update on:
Adjuvant Treatment in High Risk Resected Melanoma
Lastly, there will be a:
Melanoma Panel Discussion
Speakers

Chairperson of Tumour Board
Senior Consultant
Medical Oncology
Parkway Cancer Centre

Senior Consultant
Diagnostics Radiologist
Mount Elizabeth Hospital

Dr Brendan Pang
Consultant
Pathologist
Medical Oncology
ParkwayHealth Laboratory

Guest Speaker
Consultant Surgeon
General Surgery, Intensive Care Medicine
Mount Elizabeth Novena Specialist Centre

Panellist
Surgical Oncology
Farrer Park Hospital

Panellist
Consultant Surgeon
General Surgery
Mount Elizabeth Medical Centre

Panellist
General Surgery, Surgical Oncology
Mount Elizabeth Novena Hospital Specialist Centre
General Surgeon and Surgical Oncologist
Visiting Consultant at National Cancer Centre Singapore
Farrer Park Hospital

Panellist
Head and Neck General Surgeon
General Surgery, Surgical Oncology
Mount Elizabeth Medical Centre
DATE
Thursday, 21 October 2021
TIME
5PM – 6.30PM SGT
PLATFORM
Online Webinar
(Registration closes 1 day before the event start date.)
Parkway Cancer Centre Tumour Board
Parkway Cancer Centre (PCC) Tumour Board is a multi-disciplinary discussion platform where unusual or challenging oncology cases are presented for discussion.
For this session, the cases will be focused on:
Uncommon Gynaecological Cancers
- Vaginal Melanoma
- Uterine low grade Leiomyosarcoma
- Uterine Rhabdomyosarcoma
Speakers

Chairperson of Tumour Board
Senior Consultant
Medical Oncology
Parkway Cancer Centre

Senior Consultant
Diagnostics Radiologist
Mount Elizabeth Hospital

Dr Brendan Pang
Consultant
Pathologist
Medical Oncology
ParkwayHealth Laboratory

Senior Consultant
Radiation Oncology
Parkway Cancer Centre

Gynaecological Oncologist
Thomson Women Cancer Centre
DATE
Thursday, 25 November 2021
TIME
5PM – 6.30PM SGT
PLATFORM
Online Webinar
(Registration closes 1 day before the event start date.)
Cervical Cancer – From Screening to Treatment
Cervical cancer is the second most common cancer in women worldwide, and is now the 10th commonest women’s cancer in Singapore. The incidence here has decreased over the years due to improved economic status, improved screening and treatment of precancerous disease. This CME talk will focus on cervical cancer. A general overview will be presented, with discussion on improved cervical cancer screening test with Pap smear and HPV test. There will also be discussion on recent advances in treatment in cervical cancer.
Speakers

Senior Consultant, Medical Oncologist
Parkway Cancer Centre

Senior Consultant, Gynaecological Oncologist
Lisa Wong Women & Gynae Oncology Centre
DATE
Saturday, 25 April 2020
TIME
2PM – 3PM SGT
PLATFORM
Online Webinar
Thank you for your interest.
The webinar is over.
(Registration closes 1 hour before the event start date.)
Advances in Lung Cancer Diagnosis & Management
Lung cancer is one of the commonest cancer in both men and women. In the past, prognosis was uniformly poor. Treatment options were limited with survival less than 1 year for most patients with advanced disease. But with the development of personalised medicine, targeted therapy and immunotherapy, survival of patients has increased many fold. This significant improvement in survival outcomes is primarily due to an improved genetic characterisation of lung cancer as well as development of new targeted and immunotherapy, so much so that lung cancer is no longer just small cell vs non-small cell lung cancer but rather a heterogeneous group of diseases driven by a wide range of cancer oncogenes. As part of our multi-disciplinary CME webinar series, we invite 2 experts to discuss this complex topic with the pathologist reviewing the pathological workup of lung cancer followed by the medical oncologist to share on the latest updates in lung cancer treatment.
Speakers

Senior Consultant, Medical Oncologist
Parkway Cancer Centre

Dr Brendan Pang
Consultant, Pathologist
ParkwayHealth Laboratory
DATE
Thursday, 30 April 2020
TIME
1PM – 2PM SGT
PLATFORM
Online Webinar
Thank you for your interest.
The webinar is over.
(Registration closes 1 hour before the event start date.)
Covid-19 : An Update on the Pandemic Situation and its Impact on Cancer Patients
COVID19 has completely turned the world upside down. Since its first identification in Wuhan China in Dec 2019, COVID19 has spread around the world, affecting millions and taken the lives of hundreds of thousands of people. It is a generational crisis and its full medical, economic and human behavioural impact remains unclear. In this crisis, we witnessed healthcare workers and patients being deeply impacted by the pandemic. One group in particular are cancer patients. Cancer patients require frequent lifesaving chemotherapy and surgery, which weakens their immune system, predisposing them to more severe complications should they catch the COVID19. Five months into the crisis, it is timely for us to evaluate the data, update on the COVID19 pandemic situation, examine the impact on cancer patients and anticipate the challenges that lay ahead of us.
Speakers

Senior Consultant, Medical Oncologist
Parkway Cancer Centre

Infectious Disease Physician
Infectious Disease Specialists™
DATE
Thursday, 09 May 2020
TIME
2PM – 3PM SGT
PLATFORM
Online Webinar
Thank you for your interest.
The webinar is over.
(Registration closes 1 hour before the event start date.)
Parkway Cancer Centre Tumour Board
Parkway Cancer Centre(PCC) Tumour Board is a multi-disciplinary discussion platform where unusual or challenging oncology cases are presented for discussion. After each case presentation, we have a live interactive review of the radiology images and pathology slides by the respective experts. This is followed by an in-depth discourse of each case. To enhance the learning experience of all participants, we incorporate a short commentary on a particular interesting aspect of each case to be given by the presenter. Typically, 3-4 cases would be presented at each meeting.
Speakers

Chairperson of PCC Tumour Board
Senior Consultant, Medical Oncologist
Parkway Cancer Centre

Senior Consultant, Diagnostics Radiologist
Mount Elizabeth Hospital

Dr Brendan Pang
Consultant, Pathologist
ParkwayHealth Laboratory
DATE
Thursday, 14 May 2020
TIME
5PM – 6.30PM SGT
PLATFORM
Online Webinar
Thank you for your interest.
The webinar is over.
(Registration closes 1 hour before the event start date.)
Systemic Therapy for Advanced/Unresectable Hepatocellular Carcinoma
Hepatocellular carcinoma (HCC) is a leading cause of cancer-related death worldwide, and the burden of this cancer is expected to increase further in the coming years. Most patients with newly diagnosed with HCC are not candidates for curative treatment because of gross vascular invasion, extrahepatic metastases and/or poor liver function, highlighting the importance of systemic therapy. While the past decade has seen a paradigm shift in systemic treatment for HCC toward molecular targeted therapy, many unmet needs remain. This presentation will review the current role of molecular targeted therapy as well as immunotherapy for HCC and offer some insight to what the future may hold for the systemic treatment of this cancer.
Speakers

Senior Consultant, Medical Oncologist
Parkway Cancer Centre

Consultant, Radiologist
Parkwayhealth Radiology
DATE
Thursday, 21 May 2020
TIME
1PM – 2PM SGT
PLATFORM
Online Webinar
Thank you for your interest.
The webinar is over.
(Registration closes 1 hour before the event start date.)
Update on Cancer Pain Management
Cancer pain is a common symptom faced by cancer patients. Family physicians and specialists who are looking after cancer patients will need to be familiar with cancer pain management and the use of common analgesia. This talk will provide an update on the newer analgesia available in Singapore and also a brief on how difficult cancer pain is managed in the hospital setting.
Speakers

Dr Kok Jaan Yang
Senior Consultant, Palliative Medicine
Parkway Cancer Centre

Consultant, Anaesthesiologist
Integrative Pain Centre
DATE
Saturday, 23 May 2020
TIME
2PM – 3PM SGT
PLATFORM
Online Webinar
Thank you for your interest.
The webinar is over.
(Registration closes 1 hour before the event start date.)
What’s New in Nasopharyngeal Cancer
Nasopharyngeal cancer remains an important cancer regionally, even as mortality rates in Singapore and elsewhere are trending downwards. We review recent advances in diagnosis and treatment which have improved cure rates. We also look at current and future efforts to improve therapy whist reducing toxicities. 1. NPC – An “Asian” disease? 2. Imaging & patterns of spread 3. Current radiation therapy techniques 4. How to mitigate acute & late toxicities? 5. How to manage local recurrences 6. Concurrent chemotherapy with radiation in local disease 7. Role of induction chemotherapy in local disease 8. Systemic treatment in advanced NPC – chemotherapy, targeted therapy and immunotherapy 9. Looking ahead ….
Speakers

Senior Consultant, Medical Oncologist
Parkway Cancer Centre

Senior Consultant, Radiation Oncologist
Parkway Cancer Centre
DATE
Thursday, 28 May 2020
TIME
1PM – 2PM SGT
PLATFORM
Online Webinar
Thank you for your interest.
The webinar is over.
(Registration closes 1 hour before the event start date.)
Haematological Malignancies Identified on the Full Blood Count
The Full Blood Count (FBC) is one of the commonest tests performed in everyday clinical practice. Various abnormalities are often seen on FBC results. Sometimes, these abnormalities are a manifestation of an underlying haematological malignancy. This CME talk will focus on FBC results of patients presenting with various types of haematological cancers. We will also look at what happens after patients are referred and how they are treated.
Speakers

Senior Consultant, Haematologist
Parkway Cancer Centre
DATE
Thursday, 04 June 2020
TIME
1PM – 2PM SGT
PLATFORM
Online Webinar
Thank you for your interest.
The webinar is over.
(Registration closes 1 hour before the event start date.)
Parkway Cancer Centre Tumour Board
Parkway Cancer Centre (PCC) Tumor Board is a multi-disciplinary discussion platform where unusual or challenging oncology cases are presented for discussion. Following each case presentation, we have a live interactive review of the radiology images and pathology slides by the respective experts, followed by an in-depth discourse of each case. To enhance the learning experience for all participants, we incorporate a short commentary on a particular interesting aspect of each case to be given by the presenter. Three cases will be presented at this upcoming session: a) Challenging case of breast cancer b) Immunotherapy in solid organ transplant patient c) Cardiac amyloidosis secondary to myeloma
Speakers

Senior Consultant, Medical Oncologist
Parkway Cancer Centre

Senior Consultant, Diagnostics Radiologist
Mount Elizabeth Hospital

Dr Brendan Pang
Consultant, Pathologist
ParkwayHealth Laboratory
DATE
Thursday, 11 June 2020
TIME
5PM – 6:30PM SGT
PLATFORM
Online Webinar
Thank you for your interest.
The webinar is over.
(Registration closes 1 hour before the event start date.)
Large B-Cell Lymphoma – Different Presentations and Treatments of the Commonest Lymphoma
Diffuse large B-cell lymphoma (DLBCL) is the commonest type of lymphoma. In the last two decades there has been an increasing recognition of the different subtypes of DLBCL and how these subtypes differ in presentation, prognosis, and treatment. In this presentation, we will look at a few cases that illustrate the different DLBCL subtypes and how novel agents beyond chemotherapy are shaping treatment paradigms.
Speakers

Senior Consultant, Haematologist
Parkway Cancer Centre

Senior Consultant, Haematologist
Parkway Cancer Centre
DATE
Thursday, 18 June 2020
TIME
1PM – 2PM SGT
PLATFORM
Online Webinar
Thank you for your interest.
The webinar is over.
(Registration closes 1 hour before the event start date.)
Understanding Metastatic Colorectal Cancer
Colorectal cancer is one of the most common cancers globally. Besides an ageing population and the dietary habits of high-income countries, factors such as obesity, lack of physical exercise, and smoking increase the risk of colorectal cancer. Advancements in pathophysiological understanding as well as molecular biology have increased the array of treatment options for advanced disease. These includes targeted and immunotherapy on top of chemotherapy. These new treatment options have improved median overall survival for advanced disease to approximately 3 years compared 6 to 9 months without treatment at all.
Speakers

Senior Consultant, Medical Oncologist
Parkway Cancer Centre

Dr Brendan Pang
Consultant, Pathologist
ParkwayHealth Laboratory
DATE
Thursday, 25 June 2020
TIME
1PM – 2PM SGT
PLATFORM
Online Webinar
Thank you for your interest.
The webinar is over.
(Registration closes 1 hour before the event start date.)
Breast Cancer : Advances Made in The Last 30 Years of Care
The diagnosis and management of breast cancer have changed dramatically over the past decades in response not only to technological advances but also to cultural and social aspects of the disease. As systemic therapies for breast cancer progress in precision, radical surgical approaches for the breast and the axilla de-escalate. A multidisciplinary approach is of paramount importance from diagnosis and biopsy options to timing of surgery and irradiation; neoadjuvant or adjuvant systemic therapies and continued surveillance.
Speakers

Deputy Medical Director and Senior Consultant, Medical Oncologist
Parkway Cancer Centre

Breast Surgeon & Medical Director
Esther Chuwa BreastCare Breast Clinic
DATE
Saturday, 27 June 2020
TIME
2PM – 3PM SGT
PLATFORM
Online Webinar
Thank you for your interest.
The webinar is over.
(Registration closes 1 hour before the event start date.)
Onco-Cardiology: Cardiovascular Toxicities of Cancer and its Contemporary Treatment
Onco-cardiology is a rapidly developing new field focused on the impact of cancer and anti-cancer treatment on the human cardiovascular system. Essentially all anti-cancer agents are associated in some ways to development of cardiotoxicity, which can be divided into broadly including direct cytotoxic effects of chemotherapy and associated cardiac systolic dysfunction, cardiac ischemia, arrhythmias, and inflammatory changes of myocarditis/pericarditis. In this PCC CME webinar, we aim to highlight the different classes of common anti-cancer drugs that may pre-dispose a patient to cardio-toxicities, and expand on the diagnosis, management and follow-up of cancer patients who develop, or at risk of developing, the various forms of cardio-toxicities.
Speakers

Senior Consultant, Medical Oncologist
Parkway Cancer Centre

Cardiologist & Physician Electrophysiologist & Certified Cardiac Device Specialist
Asian Heart & Vascular Centre
DATE
Thursday, 02 July 2020
TIME
1PM – 2PM SGT
PLATFORM
Online Webinar
Thank you for your interest.
The webinar is over.
(Registration closes 1 hour before the event start date.)
Parkway Cancer Centre Tumour Board
Parkway Cancer Centre(PCC) Tumour Board is a multi-disciplinary discussion platform where unusual or challenging oncology cases are presented for discussion. After each case presentation, we have a live interactive review of the radiology images and pathology slides by the respective experts. This is followed by an in-depth discourse of each case. To enhance the learning experience of all participants, we incorporate a short commentary on a particular interesting aspect of each case to be given by the presenter. Typically, 3-4 cases would be presented at each meeting.
Speakers

Chairperson of PCC Tumour Board
Senior Consultant, Medical Oncologist
Parkway Cancer Centre

Senior Consultant, Diagnostics Radiologist
Mount Elizabeth Hospital

Dr Brendan Pang
Consultant, Pathologist
ParkwayHealth Laboratory
DATE
Thursday, 09 July 2020
TIME
5PM – 6.30PM SGT
PLATFORM
Online Webinar
Thank you for your interest.
The webinar is over.
(Registration closes 1 hour before the event start date.)
Advancing Breast Cancer Treatment by Minimising Toxicities of Chemotherapy and Radiation
An update for General Practitioners and Non Oncologists on the Role of Hormones in Breast cancer; its therapeutic manipulation and role in early and advanced breast cancer; and the recent advances in therapeutic radiation in minimising toxicities. Dr See Hui Ti will share on the discovery of Female Hormones and its role in breast cancer; followed by the historical and recent development of therapeutic anti-hormone manipulation in both early and advanced breast cancer from 1950s to 2020. She will also discuss how one determines the appropriateness of treatment. Dr Lee Kuo Ann will share on the advancement in the role of therapeutic radiation in management of breast cancer.
Speakers

Senior Consultant, Medical Oncologist
Parkway Cancer Centre

Senior Consultant, Radiation Oncologist
Parkway Cancer Centre
DATE
Thursday, 16 July 2020
TIME
1PM – 2PM SGT
PLATFORM
Online Webinar
Thank you for your interest.
The webinar is over.
(Registration closes 1 hour before the event start date.)
Ovarian Mass: Evaluation, Diagnosis & Management
Ovarian masses are common amongst pre and postmenopausal women. These can range from benign causes such ovarian cysts, fibromas and cystadenoma, to malignant causes such as ovarian cancer, germ cell tumours and sex cord stromal tumours. Ovarian cancer is the eighth most common cause of women’s cancer worldwide, resulting in 200,000 deaths per year.
This CME talk will focus on evaluation of ovarian masses. A general overview of the causes, symptoms, evaluation and management will be discussed. An update of the treatment of ovarian cancer will also be presented.
Speakers

Senior Consultant, Medical Oncologist
Parkway Cancer Centre

Senior Consultant, Gynaecological Oncologist
Gynaecology & Oncology Specialists
DATE
Thursday, 23 July 2020
TIME
1PM – 2PM SGT
PLATFORM
Online Webinar
Thank you for your interest.
The webinar is over.
(Registration closes 1 hour before the event start date.)
Lung Cancer: Screening & Early Stage Treatment
Lung cancer is the leading cause of cancer-related mortality worldwide. In Singapore, lung cancer is the most common cause of cancer deaths among men, and the second most common cause (after breast cancer) among women. More than 60% of lung cancers are diagnosed in the late stages, resulting in worse outcomes for patients. However, early stage lung cancer has a better prognosis and is potentially curative.
Previous studies had shown that screening with chest x-rays does not reduce the mortality rate from lung cancer. Currently, low-dose computed tomography (LDCT) is the only recommended screening strategy for lung cancer.
This talk will focus on screening strategies for lung cancer, and discuss treatment options for early stage lung cancer.
Speakers

Senior Consultant, Medical Oncologist
Parkway Cancer Centre

Consultant Radiologist
ParkwayHealth Radiology
DATE
Thursday, 30 July 2020
TIME
1PM – 2PM SGT
PLATFORM
Online Webinar
Thank you for your interest.
The webinar is over.
(Registration closes 1 hour before the event start date.)
Parkway Cancer Centre SARCOMA Tumour Board
Parkway Cancer Centre (PCC) Tumor Board is a multi-disciplinary discussion platform where unusual or challenging oncology cases are presented for discussion. Following each case presentation, we have a live interactive review of the radiology images and pathology slides by the respective experts, followed by an in-depth discourse of each case. To enhance the learning experience for all participants, we incorporate a short commentary on a particular interesting aspect of each case to be given by the presenters.
In this upcoming Tumor Board, we focus on the topic of bone and soft tissue sarcoma.
Five cases would be presented at this upcoming session:
a) Tibial osteosarcoma by Dr Gurpal Singh
b) Pelvic Ewing’s sarcoma by Dr Suresh Nathan
c) Gluteal liposarcoma by Dr Leon Foo
d) Abdominal Desmoplastic Small Round Cell Tumor by Dr Melissa Teo
e) Paediatric Rhabdoid Tumor by Dr Anselm Lee
Speakers

Chairperson of PCC Tumour Board
Senior Consultant, Medical Oncologist
Parkway Cancer Centre

Senior Consultant, Diagnostics Radiologist
Mount Elizabeth Hospital

Dr Brendan Pang
Consultant, Pathologist
ParkwayHealth Laboratory
DATE
Thursday, 06 August 2020
TIME
5PM – 6:30PM SGT
PLATFORM
Online Webinar
Thank you for your interest.
The webinar is over.
(Registration closes 1 hour before the event start date.)
Colorectal Cancer: Protect, Detect & Resect
These are unprecedented times. Amidst this pandemic, we must not forget that Cancer still remains the top killer in Singapore, with Colorectal Cancer being the most common locally.
Colorectal cancer is the most common cancer amongst males and second in females, with more than 1,900 new cases diagnosed annually here. Despite advances in detection and treatment strategies, majority of cases are still diagnosed late.
This presentation will address the key preventive strategies and screening methods for colorectal cancer. It will also highlight the latest surgical treatments, including laparoscopic and robotic surgery, which have helped to improve outcomes for patients.
Speakers

Senior Consultant, Medical Oncologist
Parkway Cancer Centre

Senior Consultant, General & Colorectal Surgeon
Mark Wong Surgery
DATE
Thursday, 13 August 2020
TIME
1PM – 2PM SGT
PLATFORM
Online Webinar
Thank you for your interest.
The webinar is over.
(Registration closes 1 hour before the event start date.)
Localised Prostate Cancer: Surgery or Radiation?
Prostate cancer is currently the 3rd most common cancer amongst men in Singapore, and the incidence has been rising sharply in recent years.
At the same time, advances in surgery, radiation therapy and systemic therapy have improved cure rates or reduced side effects for our patients.This webinar will focus on the two main treatment modalities for localised prostate cancer – surgery and radiation therapy.
Dr Colin Teo, a urologist, will discuss on curative Robotic Surgery for localized prostate cancer with techniques minimizing functional morbidity of urinary incontinence and erectile dysfunction
Dr Ivan Tham, a radiation oncologist, will discuss when radiation therapy would be appropriate, and how it can be delivered safely to maximise cure whilst minimising toxicity.
Speakers

Dr Colin Teo
Senior Consultant, Urologist
Colin Teo Urology

Senior Consultant, Radiation Oncologist
Parkway Cancer Centre
DATE
Thursday, 20 August 2020
TIME
1PM – 2PM SGT
PLATFORM
Online Webinar
Thank you for your interest.
The webinar is over.
(Registration closes 1 hour before the event start date.)
Parkway Cancer Centre HAEMATOLOGY Tumour Board
Parkway Cancer Centre(PCC) Tumour Board is a multi-disciplinary discussion platform where unusual or challenging oncology cases are presented for discussion.
Following each case presentation, we have a live interactive review of the radiology images and pathology slides by the respective experts, followed by an in-depth discourse of each case.
To enhance the learning experience for all participants, we incorporate a short commentary on a particular interesting aspect of each case to be given by the presenter.
Three cases will be presented at this upcoming session:
a) Multiple Myeloma with retroperitoneal fibrosis and adenocarcinoma of the stomach
b) MALT lymphoma of the eye
c) Secondary Central Nervous system lymphoma with colonic polyp
Speakers

Chairperson of PCC Tumour Board
Senior Consultant, Haematologist
Parkway Cancer Centre

Senior Consultant, Diagnostics Radiologist
Mount Elizabeth Hospital

Dr Brendan Pang
Consultant, Pathologist
ParkwayHealth Laboratory
DATE
Thursday, 03 September 2020
TIME
5PM – 6.30PM SGT
PLATFORM
Online Webinar
Thank you for your interest.
The webinar is over.
(Registration closes 1 hour before the event start date.)
Parkway Cancer Centre GASTROINTESTINAL Tumour Board
Parkway Cancer Centre(PCC) Tumour Board is a multi-disciplinary discussion platform where unusual or challenging oncology cases are presented for discussion.
Following each case presentation, we have a live interactive review of the radiology images and pathology slides by the respective experts, followed by an in-depth discourse of each case.
To enhance the learning experience for all participants, we incorporate a short commentary on a particular interesting aspect of each case to be given by the presenter.
In this Tumour Board, we focus on the topic of gastrointestinal cancers.
Three cases will be presented at this upcoming session:
a) Intra-hepatic Cholangiocarcinoma discussing the selection of cases for surgery and the role of adjuvant chemotherapy
by Dr Liau Kui Hin and Dr Foo Kian Fong
b)Low Rectal cancer discussing the role of neoadjuvant chemoradiotherapy and sphincter sparing surgical procedures
by Dr Dean Koh and Dr Foo Kian Fong
c) Gastric cancer discussing the role of neoadjuvant chemotherapy
by Dr Zee Ying Kiat
(KIV) Metastatic HER2-positive gallbladder carcinoma
by Dr Richard Quek
Speakers

Chairperson of PCC Tumour Board
Senior Consultant, Medical Oncologist
Parkway Cancer Centre

Senior Consultant, Diagnostics Radiologist
Mount Elizabeth Hospital

Dr Brendan Pang
Consultant, Pathologist
ParkwayHealth Laboratory
DATE
Thursday, 01 October 2020
TIME
5PM – 6.30PM SGT
PLATFORM
Online Webinar
Thank you for your interest.
The webinar is over.
(Registration closes 1 hour before the event start date.)
Parkway Cancer Centre GENITOURINARY Tumour Board
Parkway Cancer Centre(PCC) Tumour Board is a multi-disciplinary discussion platform where unusual or challenging oncology cases are presented for discussion.
Following each case presentation, we have a live interactive review of the radiology images and pathology slides by the respective experts, followed by an in-depth discourse of each case.
To enhance the learning experience for all participants, we incorporate a short commentary on a particular interesting aspect of each case to be given by the presenter.
In this Tumour Board, we focus on the topic of genitourinary cancers.
Three cases will be presented at this upcoming session:
a) Management of Mediastinal Non Seminomatous Germ Cell Tumor (NSGCT) with Bleomycin toxicity,
Presenter: Dr Richard Quek, Discussant: Dr Tan Aik Hau.
b) Metastatic renal cell carcinoma after failing first-line targeted therapy,
Presenter: Dr Ang Peng Tiam, Discussant: Dr Zee Ying Kiat.
c) Metastatic prostate cancer with disease progression after multiple lines of treatment,
Presenter: Dr Ang Peng Tiam, Discussant: Dr Tan Yeh Hong and Dr Ong Seng Chuan.
Speakers

Chairperson of PCC Tumour Board
Deputy Medical Director & Senior Consultant, Medical Oncologist
Parkway Cancer Centre

Senior Consultant, Diagnostics Radiologist
Mount Elizabeth Hospital

Dr Brendan Pang
Consultant, Pathologist
ParkwayHealth Laboratory
DATE
Thursday, 05 November 2020
TIME
5PM – 6.30PM SGT
PLATFORM
Online Webinar
Thank you for your interest.
The webinar is over.
(Registration closes 1 hour before the event start date.)
Parkway Cancer Centre Tumour Board & Oncology Update
Parkway Cancer Centre (PCC) Tumour Board is a multi-disciplinary discussion platform where unusual or challenging oncology cases are presented for discussion. To enhance the learning experience for all participants, we incorporate an oncology update.
For this session, the oncology update will focus on Mucosal Melanoma, to be presented by Dr Richard Quek, where he will provide a succinct overview on the challenges associated with the management of mucosal melanomas.
Speakers

Chairperson of PCC Tumour Board
Senior Consultant
Medical Oncology
Parkway Cancer Centre

Senior Consultant, Diagnostics Radiologist
Mount Elizabeth Hospital

Dr Brendan Pang
Consultant, Pathologist
ParkwayHealth Laboratory
DATE
Thursday, 25 February 2021
TIME
5PM – 6.30PM SGT
PLATFORM
Online Webinar
(Registration closes 1 hour before the event start date.)
Thank you for your interest.
The webinar is over.
Pregnancy and Breast Cancer
Breast Cancer in general is the commonest cancer in women, and there is a trend towards a younger age. Conversely there is also a trend in childbearing in older women. What can one do when one gets diagnosed with breast cancer during pregnancy?
Understand the considerations of management of cancer in ladies of child bearing age and during pregnancy in this webinar.
Speakers

Senior Consultant
Medical Oncology
Parkway Cancer Centre
DATE
Thursday, 11 March 2021
TIME
1PM – 2PM SGT
PLATFORM
Online Webinar
(Registration closes 1 hour before the event start date.)
Thank you for your interest.
The webinar is over.
Tumour Board & Oncology Update
Parkway Cancer Centre (PCC) Tumour Board is a multi-disciplinary discussion platform where unusual or challenging oncology cases are presented for discussion. To enhance the learning experience for all participants, we incorporate an oncology update.
For this session, the oncology update will focus on Head & Neck Cancer, to be presented by Dr Tan Ngian Chye.
Speakers

Senior Consultant
Medical Oncology
Parkway Cancer Centre

Senior Consultant
Diagnostics Radiologist
Mount Elizabeth Hospital

Dr Brendan Pang
Consultant
Pathologist
ParkwayHealth Laboratory

Senior Consultant
Head & Neck and General Surgeon
Mount Elizabeth Novena Hospital

Medical Director & Senior Consultant
Vascular & Endovascular Surgeon General Surgery
Mount Elizabeth Novena Hospital
DATE
Thursday, 18 March 2021
TIME
5PM – 6.30PM SGT
PLATFORM
Online Webinar
(Registration closes 1 hour before the event start date.)
Thank you for your interest.
The webinar is over.

Ovarian Cancer: Diagnosis and Treatments in 2021
Ovarian Cancer is the eighth most common cancer in the world. It has a high mortality rate, with 185 000...

What’s New in Nasopharyngeal Cancer (2021)
In a CME Talk, Dr Ivan Tham presented some insights into new developments in the diagnosis & treatment of NPC....

Lung Cancer: Screening & Early-stage Treatment in Singapore 2020
In recent years, we have seen advances in the detection & early-stage treatment of lung cancer. Learn the latest updates...

Understanding Metastatic Colorectal Cancer: Treatment Options in 2020
With advances in medical science & more personalised treatment, targeted therapy in combination with chemotherapy has increased overall survival for...

Cardiovascular Toxicities of Cancer and its Comtemporary Treatment
Dr Richard Quek & Dr Jeremy Chow discussed the toxicities of systemic anti-cancer treatment and the side effects to the...
Cancer Pain Management: 3-Step Analgesic Ladder
Learn the general principles of cancer pain management, the use of 3-step analgesic ladder for cancer pain & some practical...

PCC’s First Online Continuing Medical Education (CME) Webinar
Entitled “Understanding Cancer and Beyond 2020”, the CME empowerment series serves to help doctors gain a better understanding of cancer...

Lung Cancer: More Options for Treatment in 2020
A better understanding of lung cancer has led to more diagnostic & treatment options for patients, and a much better...

Digging Deeper into the Causes of Cancer
Tumour board cases at Parkway Cancer Centre reflect the need to understand cancers at anatomical as well as molecular levels....

Coronavirus (COVID-19): Effect & Impact on Cancer Patients
Are cancer patients more likely to catch Covid-19? Experts discuss the diagnosis & treatment of the coronavirus and how it...
Cervical Cancer: HPV Vaccination, Screening Methods & Treatments
Doctors stress the need for vaccination & screening, as HPV is the main cause of cervical cancer. These have helped...
Learn About Cancer
Cancer Support
© 2025 Parkway Cancer Centre